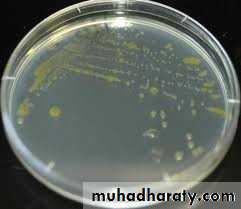
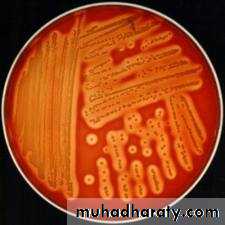
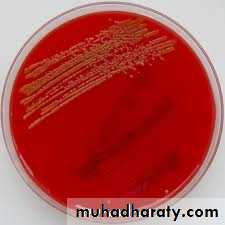
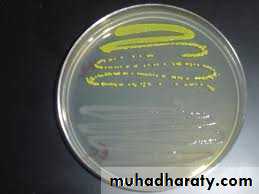
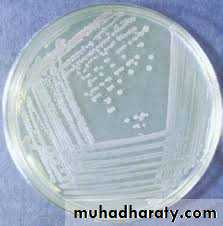

LAB:3CULTURE MEDIA
CULTURE MEDIA- Culture media are used for the recognition and identification of microorganism. The media are contained either in test tubes, plates (Petri dishes) flasks or screw capped bottles which must be thoroughly cleaned before use, then the medium and the container are subsequently sterilized by heat.
Blood agar and nutrient agar
(Solid culture medium)nutrient broth
(Fluid culture medium)Common ingredients of culture media
• 1. Peptone• 2.Meat extract
• 3.Nacl
• 4. Agar agar a. Melting point 92-95 c
• b. solidifing point 42-45 c c. concentration 1.5-2%
Most pathogenic bacteria have restricted pH (7.2 – 7.4 ) . Therefore, pH of the media should be adjusted using 10% NaOH or HCL
• TYPES OF CULTURE MEDIA :
• - Culture media can be classified according to:• A - Physical state ( consistency ) of the media
• 1.Liquid (Fluid) media e.g. nutrient broth, peptone water, brain heart infusion . They are commonly used for primary cultivation.
• 2.Solid media e.g. nutrient agar ,blood agar, MacConkey's agar which are commonly used for cultivation of bacteria.
• 3. Semisolid media used for cultivation of spirochetes and to study motility. They contain 0.4 – 0.8 % of agar agar.
Blood agar and nutrient agar
(Solid culture medium)nutrient broth
(Fluid culture medium)B. According to the use of media
• 1)Simple or basal media e.g. nutrient agar and nutrient broth.• They are used for the cultivation of common microorganism but not for the fastidious bacteria.
Nutrient agar Nutrient broth
Simple culture media
ENRICHED MEDIA :-
-Simple media enriched with appropriate substance ,e.g. Blood ,glucose ,serum and ascetic fluid ,most commonly used to cultivate fastidious microorganism like streptococci.2)special-purpose media e.g. enriched, selective, differential, transport, sensitivity test, etc…
Chocolate agar Blood agar (Enriched media)
SELECTIVE MEDIA
-Containing inhibitory substance ( e.g. bile salt ,antibiotic, dyes…etc) which favour the growth of concerned microorganism and inhibit the growth of other . e.g. Maconkey's agar, Potassium tellurite agar, Bismuth sulphite agar , Deoxycholate citrate agar…etc
Slective medium for gram negative bacilli (contains bile salts which inhibit the growth of gram positive microorganisms)
-Certain species produce characteristic growth that can be easily recognized, or can produce certain effects in the media e.g. hemolytic and non-hemolytic species on blood agar ,MacConkeys agar differintiates between lactose fermenter and non lactose fermenter gram negative bacilli.
DIFFERENTIAL MEDIA
Haemolytic bacteria on blood agar
Non haemolyticbacteria on blood agarMacConkey′s agar (selective and differential medium)selective for gram negative bacilli and differentiate between lactose fermenter and non lactose fermenter gram negative bacilli)
Staphylococcus albus(white colonies) on nutrient agar
Staphylococcus citreus (lemon yellow colonies) on nutrient agarStaphylococcus aureus (golden yellow colonies) on nutrient agar
Antibiotic susceptibility testing on Mueller-Hinton agar- This test is used to know the appropriate antimicrobial agents to be used for the treatment of the causative bacteria.
Disk diffusion test
-The culture media is inoculated by the pathogenic bacteria and a paper discs impregnated by different type of antibiotic (Each disc for specific antimicrobial agent eg disc for ampicillin and other for gentamicin, amikacin rifampicin …etc) are placed on this culture media.-The culture is incubated at 37 C for 24-48 hr according to the type of mo. The test results are read as the following:
1- A Zone of inhibition of growth (no growth around the disc) the bacteria is sensitive to this agent.
2- If the growth of mo reached the edge of the disc this mo is resistant to this antimicrobial drug.
Zone of inhibition
No growth of m.osensitive
No zone of no no inhibition
Growth to the edge of the disc
resistant